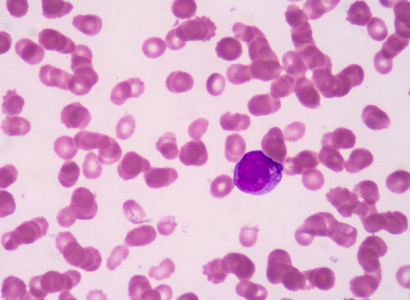
早幼粒细胞照片

早幼粒细胞

实验诊断学 早幼粒细胞
图片尺寸1080x810
一例急性早幼粒细胞白血病|细胞白血病|血常规|颗粒型|幼粒|骨髓
图片尺寸1080x1441
实验诊断学 早幼粒细胞 ↓ ↑ 中幼红细胞
图片尺寸1080x810
早幼粒细胞
图片尺寸640x480
【原创】正常早幼粒和异常早幼粒细胞区别
图片尺寸639x772
早幼粒细胞 03
图片尺寸650x484
早幼粒细胞
图片尺寸1080x810
答案: :巨早幼红细胞
图片尺寸896x896
看图识细胞(第45期)_颗粒
图片尺寸1080x853
早幼粒细胞照片
图片尺寸410x300
导语:急性早幼粒细胞白血病是一种以早幼粒细胞分化受阻为主要特征的
图片尺寸640x400
体检中心健康体检发现急性早幼粒细胞白血病一例
图片尺寸1600x1200
年细胞形态学培训考试 a:原始粒细胞 b:原始单核细胞 c:早幼粒细胞 d
图片尺寸2491x1782
看图识细胞(第45期)_颗粒
图片尺寸1080x810
早幼粒细胞图片
图片尺寸546x480
早幼粒细胞.血涂片通常用作随访试验(cb)
图片尺寸700x586
图6 早幼粒细胞
图片尺寸1111x880
看图识细胞(第45期)_颗粒
图片尺寸1080x886
照片名称:早幼粒细胞
图片尺寸800x600
血细胞形态特征ppt
图片尺寸1080x810